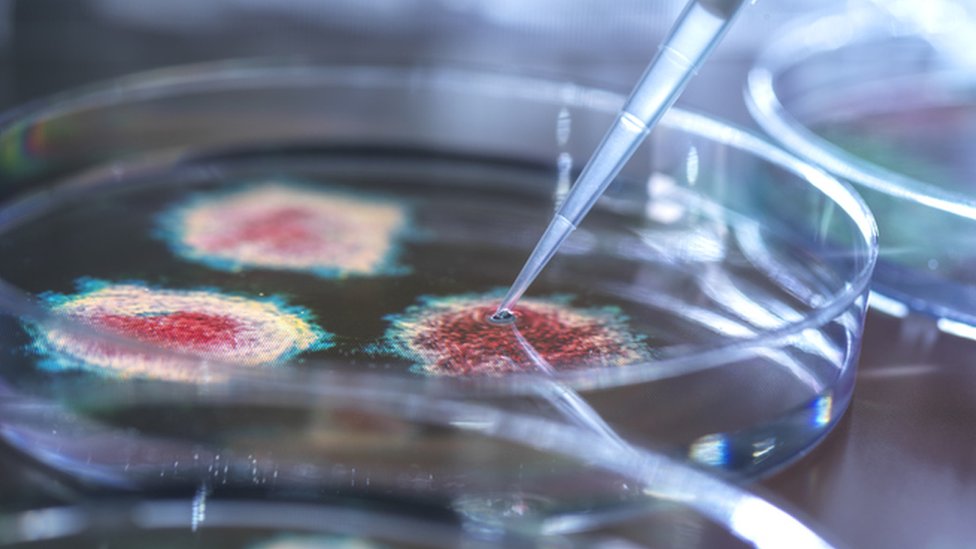
கொரோனா வைரஸ் கோப்புப் படம்

கொரோனா வைரஸ் B.1.1.529 திரிபு: 50 மரபணு பிறழ்வுகள், ஆபத்துகள் பற்றி அறிவியல் உலகம் கூறுவதென்ன?
நாம் மீண்டும் நமக்கு பழக்கப்பட்ட இடத்திற்கே வந்துள்ளோம், கொரோனா வைரஸின் புதிய திரிபு குறித்த கவலை அதிகரித்து வருகிறது.
கொரோனா வைரஸின் இந்த புதிய திரிபு இதுவரை கண்டுபிடிக்கப்பட்ட திரிபுகளிலேயே மிக அதிக எண்ணிக்கையிலான மரபணு பிறழ்வுகளைக் கொண்டது. இது மிகவும் அச்சுறுத்தக் கூடியது என ஓர் அறிவியலாளர் இதை விவரித்துள்ளார், மற்றொருவரோ தாங்கள் கண்ட திரிபுகளிலேயே இதுதான் மிகவும் மோசமான திரிபு என என்னிடம் கூறினார்.
இது இந்தத் திரிபு தொடர்பான விவரங்கள் வெளிவரத் தொடங்கியிருக்கும் ஆரம்ப நாட்களில் கூறப்பட்டவை. இத்திரிபால் பாதிக்கப்பட்டிருப்பவர்கள் பெரும்பாலும் தென் ஆப்பிரிக்காவின் ஒரு மாகாணத்தைச் சேர்ந்தவர்களாக இருக்கிறார்கள். ஆனால் இந்தத் திரிபு மேற்கொண்டு பரவியிருக்கலாம் என்பதற்கான சில குறிப்புகளைக் காண முடிகிறது.
இந்தப் புதிய திரிபு எவ்வளவு வேகமாக பரவும், கொரோனா தடுப்பூசிகளால் மனிதர்களுக்கு கிடைத்திருக்கும் பாதுகாப்பு அம்சங்களை இது எப்படி கடக்கிறது, இந்த புதிய கொரோனா திரிபை கட்டுப்படுத்த என்ன செய்ய வேண்டும் என பல கேள்விகள் இப்போது எழுகின்றன.
B.1.1.529 கொரோனா திரிபு குறித்து பல்வேறு ஊகங்கள் வலம் வருகின்றன, ஆனால் வெகுசில தெளிவான விடைகள் மட்டுமே இருக்கின்றன.
B.1.1.529 திரிபு குறித்து நமக்கு என்ன தெரியும்?
B.1.1.529 என்றழைக்கப்படும் இந்த புதிய கொரோனா திரிபுக்கு, உலக சுகாதார அமைப்பு வெள்ளிக்கிழமை ஒரு புதிய கிரேக்க பெயரை சூட்ட உள்ளது.
"புதிய கொரோனா திரிபில் வழக்கத்துக்கு மாறாக பல்வேறு பிறழ்வுகள் உள்ளன. இது மற்ற கொரோனா திரிபுகளிலிருந்து மிகவும் வேறுபட்டதாக உள்ளது" என தென்னாப்பிரிக்காவில் உள்ள சென்டர் ஃபார் எபிடமிக் ரெஸ்பான்ஸ் அண்ட் இன்னொவேஷன் என்கிற அமைப்பின் இயக்குநர் பேராசிரியர் டுளியோ டி ஒலிவெரியா கூறினார்.
- இரு டோஸ் தடுப்பூசி செலுத்திக் கொண்டவர்கள் கூட கொரோனாவை பரப்பலாம் - அதிர்ச்சிகர புது ஆய்வு
- கொரோனா பரவலை தடுக்காவிட்டால் ஐரோப்பாவில் 5 லட்சம் பேர் பலியாகலாம்: WHO எச்சரிக்கை
இந்த கொரோனா திரிபு எங்களை ஆச்சரியத்படுத்துகிறது. இத்திரிபு, அதன் பரிணாம வளர்ச்சியில் மிகப் பெரும் பாய்ச்சலை கண்டுள்ளது. நாங்கள் எதிர்பார்த்ததை விட அதிக அளவிலான பிறழ்வுகளை கொண்டுள்ளது என்றும் கூறினார்.
இந்த புதிய கொரோனா வைரஸ் திரிபில் 50 மரபணு பிறழ்வுகள் உள்ளன என்றும், ஸ்பைக் புரோட்டின் இடையில் 30க்கும் மேற்பட்ட பிறழ்வுகள் இருப்பதாகவும் ஒரு பத்திரிகையாளர் சந்திப்பில் குறிப்பிட்டார் பேராசிரியர் டுளியோ டி ஒலிவெரியா.
கொரோனா தடுப்பூசிகள் இந்த ஸ்பைக் புரத இழையைத்தான் இலக்கு வைக்கின்றன. அதேபோல மனிதர்களின் உடலுக்குள் ஊடுறுவ கொரோனா வைரஸ் இந்த ஸ்பைக் புரத இழையைத்தான் பயன்படுத்துகின்றது.
மனிதர்களின் உடலோடு முதலில் தொடர்பு கொள்ளும் ரெசப்டாரில் 10 பிறழ்வுகள் உள்ளன. உலகை உலுக்கிய கொரோனா வைரஸின் டெல்டா திரிபிலேயே ரெசப்டார்களில் இரண்டு பிறழ்வுகள் மட்டுமே இருந்தது.
கொரோனா வைரஸை தோற்கடிக்க முடியாத ஒரு நோயாளியின் உடலிலிருந்து இத்தனை அதிக பிறழ்வுகள் ஏற்பட்டிருக்கலாம்.
பொதுவாக அதிக பிறழ்வுகள் என்றாலே ஆபத்தானவை என்று பொருள் அல்ல, அந்த பிறழ்வுகள் என்ன செய்கின்றன என்பதை அறிந்து கொள்வது அவசியம்.
- தெற்காசியர்களிடம் அதிகமுள்ள கொரோனா பாதிக்கும் ஜீன் - தடுப்பூசி வேலை செய்யுமா?
- கொரோனா தடுப்பூசிக்குப் பின் ஏற்படும் அரிய நரம்பியல் நோய் - மருத்துவ உலகம் கூறுவதென்ன?
ஆனால் இங்கு பிரச்னை என்னவெனில் சீனாவின் வூஹான் மாகாணத்தில் கண்டுபிடிக்கப்பட்ட கொரோனா வைரஸிலிருந்து, இந்த திரிபு மிகப்பெரிய மாற்றத்தைக் கண்டுள்ளது. அதாவது கொரோனா வைரஸின் ஒரிஜினல் ஸ்டரெயின் என்றழைக்கப்படும். ஆரம்பகால இழைகளைப் பயன்படுத்தி தயாரிக்கப்பட்ட கொரோனா தடுப்பூசிகள் B.1.1.529 கொரோனா திரிபுக்கு எதிராக அதிக செயல் திறனற்றுப் போகலாம்.
இந்த புதிய திரிபில் காணப்படும் சில பிறழ்வுகள், ஏற்கனவே வேறு சில பிறழ்வுகளில் காணப்பட்டுள்ளன. எனவே அந்த பிறழ்வுகள் எப்படி செயல்படலாம் என சில விவரங்களை நமக்கு வழங்குகின்றன.
"இந்த கொரோனா வைரஸ் திரிபு பரவும் தன்மையை அதிகரித்திருக்கலாம், ஒரு நபரிடமிருந்து மற்றொரு நபருக்கு வேகமாகப் பரவம் திறனை அதிகரித்திருக்கலாம் என கவலை அளிக்கிறது, ஆனால் இத்திரிபு நோயெதிர்ப்பு மண்டலத்தின் சில பகுதிகளை வெற்றிகரமாக கடக்கலாம்" என தென்னாப்பிரிக்காவில் உள்ள க்வாசுலு நடல் பல்கலைக்கழகத்தைச் சேர்ந்த பேராசிரியர் ரிச்சர்ட் லெஸ்செல்ஸ் கூறினார்.
காகிதத்தில் மிகவும் அச்சுறுத்த கூடியதாக தோன்றும் பல கொரோனா திரிபுகள், எதார்த்தத்தில் ஒன்றுமில்லாமல் போய் உள்ளன. அதற்கு பல உதாரணங்கள் உள்ளன. கொரோனா வைரஸின் பீட்டா (beta) திரிபு இந்த ஆண்டின் தொடக்கத்தில் மிகவும் அச்சுறுத்த கூடியதாக மக்களின் கவலைக்குரியதாக இருந்தது. அத்திரிபு மனிதர்களின் நோய் எதிர்ப்பு மண்டலத்தில் சிக்காமல் தப்பிப்பதில் சிறந்து விளங்கியது. ஆனால் எதார்த்தத்தில் அதிவேகமாக பரவக்கூடிய டெல்டா திரிபு உலகை தவிக்க வைத்தது.
"பீட்டா திரிபு நோயெதிர்ப்பு மண்டலத்தை கடப்பதில் மட்டுமே சிறந்து விளங்கியது, ஆனால் டெல்டா (delta) திரிபோ தொற்றுத்தன்மை மற்றும் ஓரளவுக்கு நோய் எதிர்ப்பு மண்டலத்திலிருந்து தப்பிக்கும் திறன் என இரண்டையும் கொண்டிருந்தது. இந்த இரு திறன்களும் கொரோனா வைரஸ் பரவலை அடுத்த கட்டத்துக்கு எடுத்துச் சென்றன" என்கிறார் கேம்பிரிட்ஜ் பல்கலைக்கழகத்தைச் சேர்ந்த பேராசிரியர் ரவி குப்தா.
- "தமிழ்நாட்டில் 2 மாதத்தில் கொரோனாவால் இறந்தோரில் 87 சதவீதம் பேர் தடுப்பூசி போடாதவர்கள்"
- கொரோனா தடுப்பூசி பக்கவிளைவுகள் கண்டுபிடிப்பு: ’நோயின் ஆபத்தை ஒப்பிடுகையில் குறைவு’
ஆய்வகங்களில் மேற்கொள்ளப்படும் ஆராய்ச்சிகள் இது தொடர்பான தெளிவுகளை வழங்கும், ஆனால் எதார்த்தத்தில் உலகில் பரவும் வைரஸை கண்காணிப்பதன் மூலம் இத்திரிபு தொடர்பான விடை விரைவாகக் கிடைக்கும். இது அரம்ப கட்டம் என்பதால், இப்போது எந்த ஒரு முடிவுக்கும் வர முடியாது.
தென்னாப்பிரிக்காவின் கெளடெங் மாகாணத்தில் 77 பேரும், போட்ஸ்வானாவில் நான்கு பேரும், ஹாங்காங்கில் ஒருவரும் இத்திரிபால் பாதிக்கப்பட்டிருக்கின்றனர். அனைவரும் தென்னாப்பிரிக்கா உடன் பயணத் தொடர்புடையவர்களாக உள்ளனர்.
இத்திரிபு இன்னும் பரவலாக பரவியிருப்பதற்கான குறிப்புகள் உள்ளன. இந்த திரிபை முழுமையான மரபணு சோதனை செய்யாமல், நிலையான பரிசோதனைகளிலேயே (Standard Test) இந்த திரிபை கண்டுபிடிக்க முடியும்.
இச்சோதனையில் கெளடெங் மாகாணத்தில் கொரோனாவால் பாதிக்கப்பட்டு இருப்பவர்களில் 90% பேர் இத்திரிபால் பாதிக்கப்பட்டிருக்கலாம் என்றும், மற்ற மாகாணங்களிலும் இத்திரிபு பரவியிருக்கலாம் என்றும் இச்சோதனை பரிந்துரைக்கிறது.
டெல்டா திரிபை விட இத்திரிபு அதிவேகமாக பரவக் கூடியதா, அதன் தீவிரத்தன்மை என்ன, தடுப்பூசிகளால் கிடைக்கும் பாதுகாப்பை இத்திரிபால் எந்த அளவுக்கு கடக்க முடியும் என்பதை எல்லாம் அச்சோதனை நமக்கு வெளிப்படுத்தாது.
மேலும், அதிகம் தடுப்பூசி செலுத்திக் கொண்டுள்ள நாடுகளில் இத்திரிபு எப்படி பரவும் என்பது குறித்த தகவல்களையும் வெளிப்படுத்தாது. தென்னாப்பிரிகாவில் 24% பேர் மட்டுமே முழுமையாக கொரோனா தடுப்பூசி செலுத்திக் கொண்டனர் என்றாலும், அந்நாட்டில் பலருக்கும் கொரோனா தொற்று ஏற்பட்டது என்பது குறிப்பிடத்தக்கது.
இத்திரிபை நெருக்கமாக கண்காணிக்க வேண்டும், அதோடு என்ன செய்ய வேண்டும், எப்போது செய்ய வேண்டும் என ஆழமாக கேள்விகளைக் கேட்க வேண்டும். நமக்கு எல்லா விடைகளும் கிடைக்கும் வரை நாம் காத்திருக்க முடியாது என்பது இந்த பெருந்தொற்றில் நாம் கற்றுக் கொண்ட பாடம்.
பிற செய்திகள்:
- வீரப்பன் அண்ணன் மாதையனை விடுதலை செய்ய 34 ஆண்டுகளுக்குப் பிறகும் நீடிக்கும் சிக்கல்
- பறக்கும் மர்மப் பொருள்கள் வேற்றுக்கிரக வேலையா? ஆராய குழு அமைத்த அமெரிக்க ராணுவம்
- தமிழக மழை: சடங்காகிறதா மத்திய குழு ஆய்வு? கேட்பது 100 கிடைப்பது 10 - விரிவான அலசல்
- பாலியல் தொல்லை: அதிகரிக்கும் மாணவ சமூக தற்கொலை - தீர்வு என்ன?
- சிறார் பாலியல் குற்றவாளிக்கு தண்டனை குறைப்பு: நிபுணர்கள் எதிர்வி
சமூக ஊடகங்களில் பிபிசி தமிழ் :
- ஃபேஸ்புக் : பிபிசி தமிழ் ஃபேஸ்புக்
- டிவிட்டர் : பிபிசி தமிழ் ட்விட்டர்
- இன்ஸ்டாகிராம் : பிபிசி தமிழ் இன்ஸ்டாகிராம்
- யு டியூப் : பிபிசி தமிழ் யுடியூப்

Click it and Unblock the Notifications